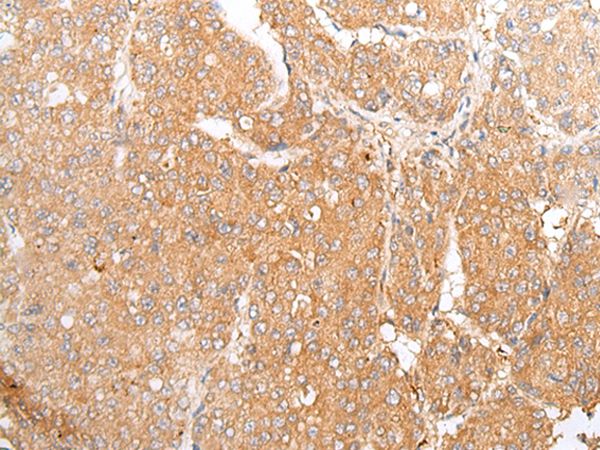
Anti-TMEM107 Antibody

IHC-plus(tm) TMEM107 Antibody
LS-B10131
ApplicationsImmunoFluorescence, Western Blot, ELISA, ImmunoHistoChemistry, ImmunoHistoChemistry Paraffin
Product group Antibodies
TargetTMEM107
Overview
- SupplierLifeSpan BioSciences
- Product NameIHC-plus(tm) TMEM107 Antibody
- Delivery Days Customer14
- Application Supplier NoteTMEM107 antibody can be used for detection of TMEM107 by Western blot at 1 - 2 ug/ml. Antibody validated: Western Blot in human samples; Immunohistochemistry in human samples and Immunofluorescence in human samples. All other applications and species not yet tested. Western Blot: Predicted: 16 kDa Observed: 19kDa. ELISA, IF (20 µg/ml), IHC, IHC-P (10 µg/ml), WB (1 µg/ml) TMEM107 antibody can be used for detection of TMEM107 by Western blot at 1 - 2 ug/ml. Antibody validated: Western Blot in human samples; Immunohistochemistry in human samples and Immunofluorescence in human samples. All other applications and species not yet tested. Western Blot: Predicted: 16 kDa Observed: 19kDa
- ApplicationsImmunoFluorescence, Western Blot, ELISA, ImmunoHistoChemistry, ImmunoHistoChemistry Paraffin
- CertificationResearch Use Only
- ClonalityPolyclonal
- Concentration1 mg/ml
- ConjugateUnconjugated
- Estimated Purity...
- Gene ID84314
- Target nameTMEM107
- Target descriptiontransmembrane protein 107
- Target synonymsGRVS638, JBTS29, MKS13, PRO1268, transmembrane protein 107
- HostRabbit
- IsotypeIgG
- Storage Instruction-20°C,2°C to 8°C
- UNSPSC12352203